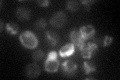
YGR174C
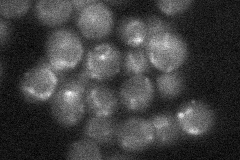
YGR174C
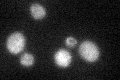
YGR174C

View description
Mitochondrial protein required for assembly of ubiquinol cytochrome-c reductase complex (cytochrome bc1 complex); interacts with Cbp3p and function is partially redundant with that of Cbp3p
Localization:
Intensity:
Fold change:
Significance:
-
C’ GFP library in SD
mitochondria19.64 -
N' NOP1pr-GFP in SD

mitochondria88.2001 -
N' TEF2pr-mCherry in SD

missing0 -
N' NATIVEpr-GFP in SD
mitochondria22.6156 -
N' TEF2pr-VC and Cyto-VN in SD

#N/A0 -
C’ GFP library in SD+DTT
mitochondria18.250.92No -
C’ GFP library in SD+H2O2

mitochondria15.730.8No -
C’ GFP library in Starvation Media

mitochondria31.651.61No -
C’ GFP library on the background of Pup2-DaMP

mitochondria -
C’ GFP library on the background of CCT mutant

mitochondria16.56760.843127No
